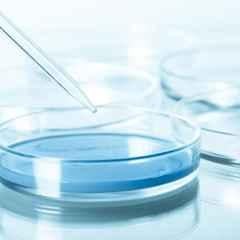

Electrical & Appliances
Industrial Tools
Office Supplies
Agri & Gardening
Medical & Lab Supplies
Safety Supplies
Construction Materials
Automotive
Packaging & Material Handling

Hover to Zoom
₹355 (Incl. of all taxes)
₹300 ₹55 GST
MRP ₹1,125 68% OFF
Sign Up & Earn 10 Mogli Coins
& save extra money on your next purchase.
for Your Purchase
All Coupons & Offers
India’s Leading B2B Online Store
Avg. Rating
Orders Delivered
Happy Customers
ETO Sterilized & Ready for Immediate Lab Use.
Lightweight & Stackable for Convenient Storage.
Brand | |
Depth | 15 mm |
Ideal For | Medical & Laboratory |
Item Code | MMPD010 |
Outer Diameter | 90 mm |
Country of origin | India |
Manufacturer Details | Mittal Meditech,1ST Floor, Plot No. 105, HSIIDC Industrial Area Sector 31 Faridabad -121003(HR) |
Packer Details | Mittal Meditech,1ST Floor, Plot No. 105, HSIIDC Industrial Area Sector 31 Faridabad -121003(HR) |
Common/Generic Name | Petri Dishes |
Dimensions LxWxH | 12.5x8x19 cm |
Weight | 0.156 kg |
Experience unparalleled convenience and efficiency in your lab with Mittal Meditech 90x15mm ETO Sterile Petri Dishes with Lids (MMPD010). These Petri dishes are sterilized using ethylene oxide gas, making them ready for immediate use in medical and laboratory settings. With a depth of 15mm and an outer diameter of 90mm, these lightweight dishes are stackable for easy storage. Ensure optimal conditions for your microbial culture experiments with this pack of 10 high-quality Petri dishes from Mittal Meditech. Elevate your scientific processes with these reliable and durable Petri dishes.
Browse through the extensive list of Petri Dishes at Moglix. Shop online for other Mittal Meditech Petri Dishes. available at Moglix in the lowest price range.

Purchase item in bulk quantity
Get at best price for your business





































₹355 (Incl. of all taxes)
₹300 ₹55 GST
MRP ₹1,125 68% OFF
Check serviceability at your location